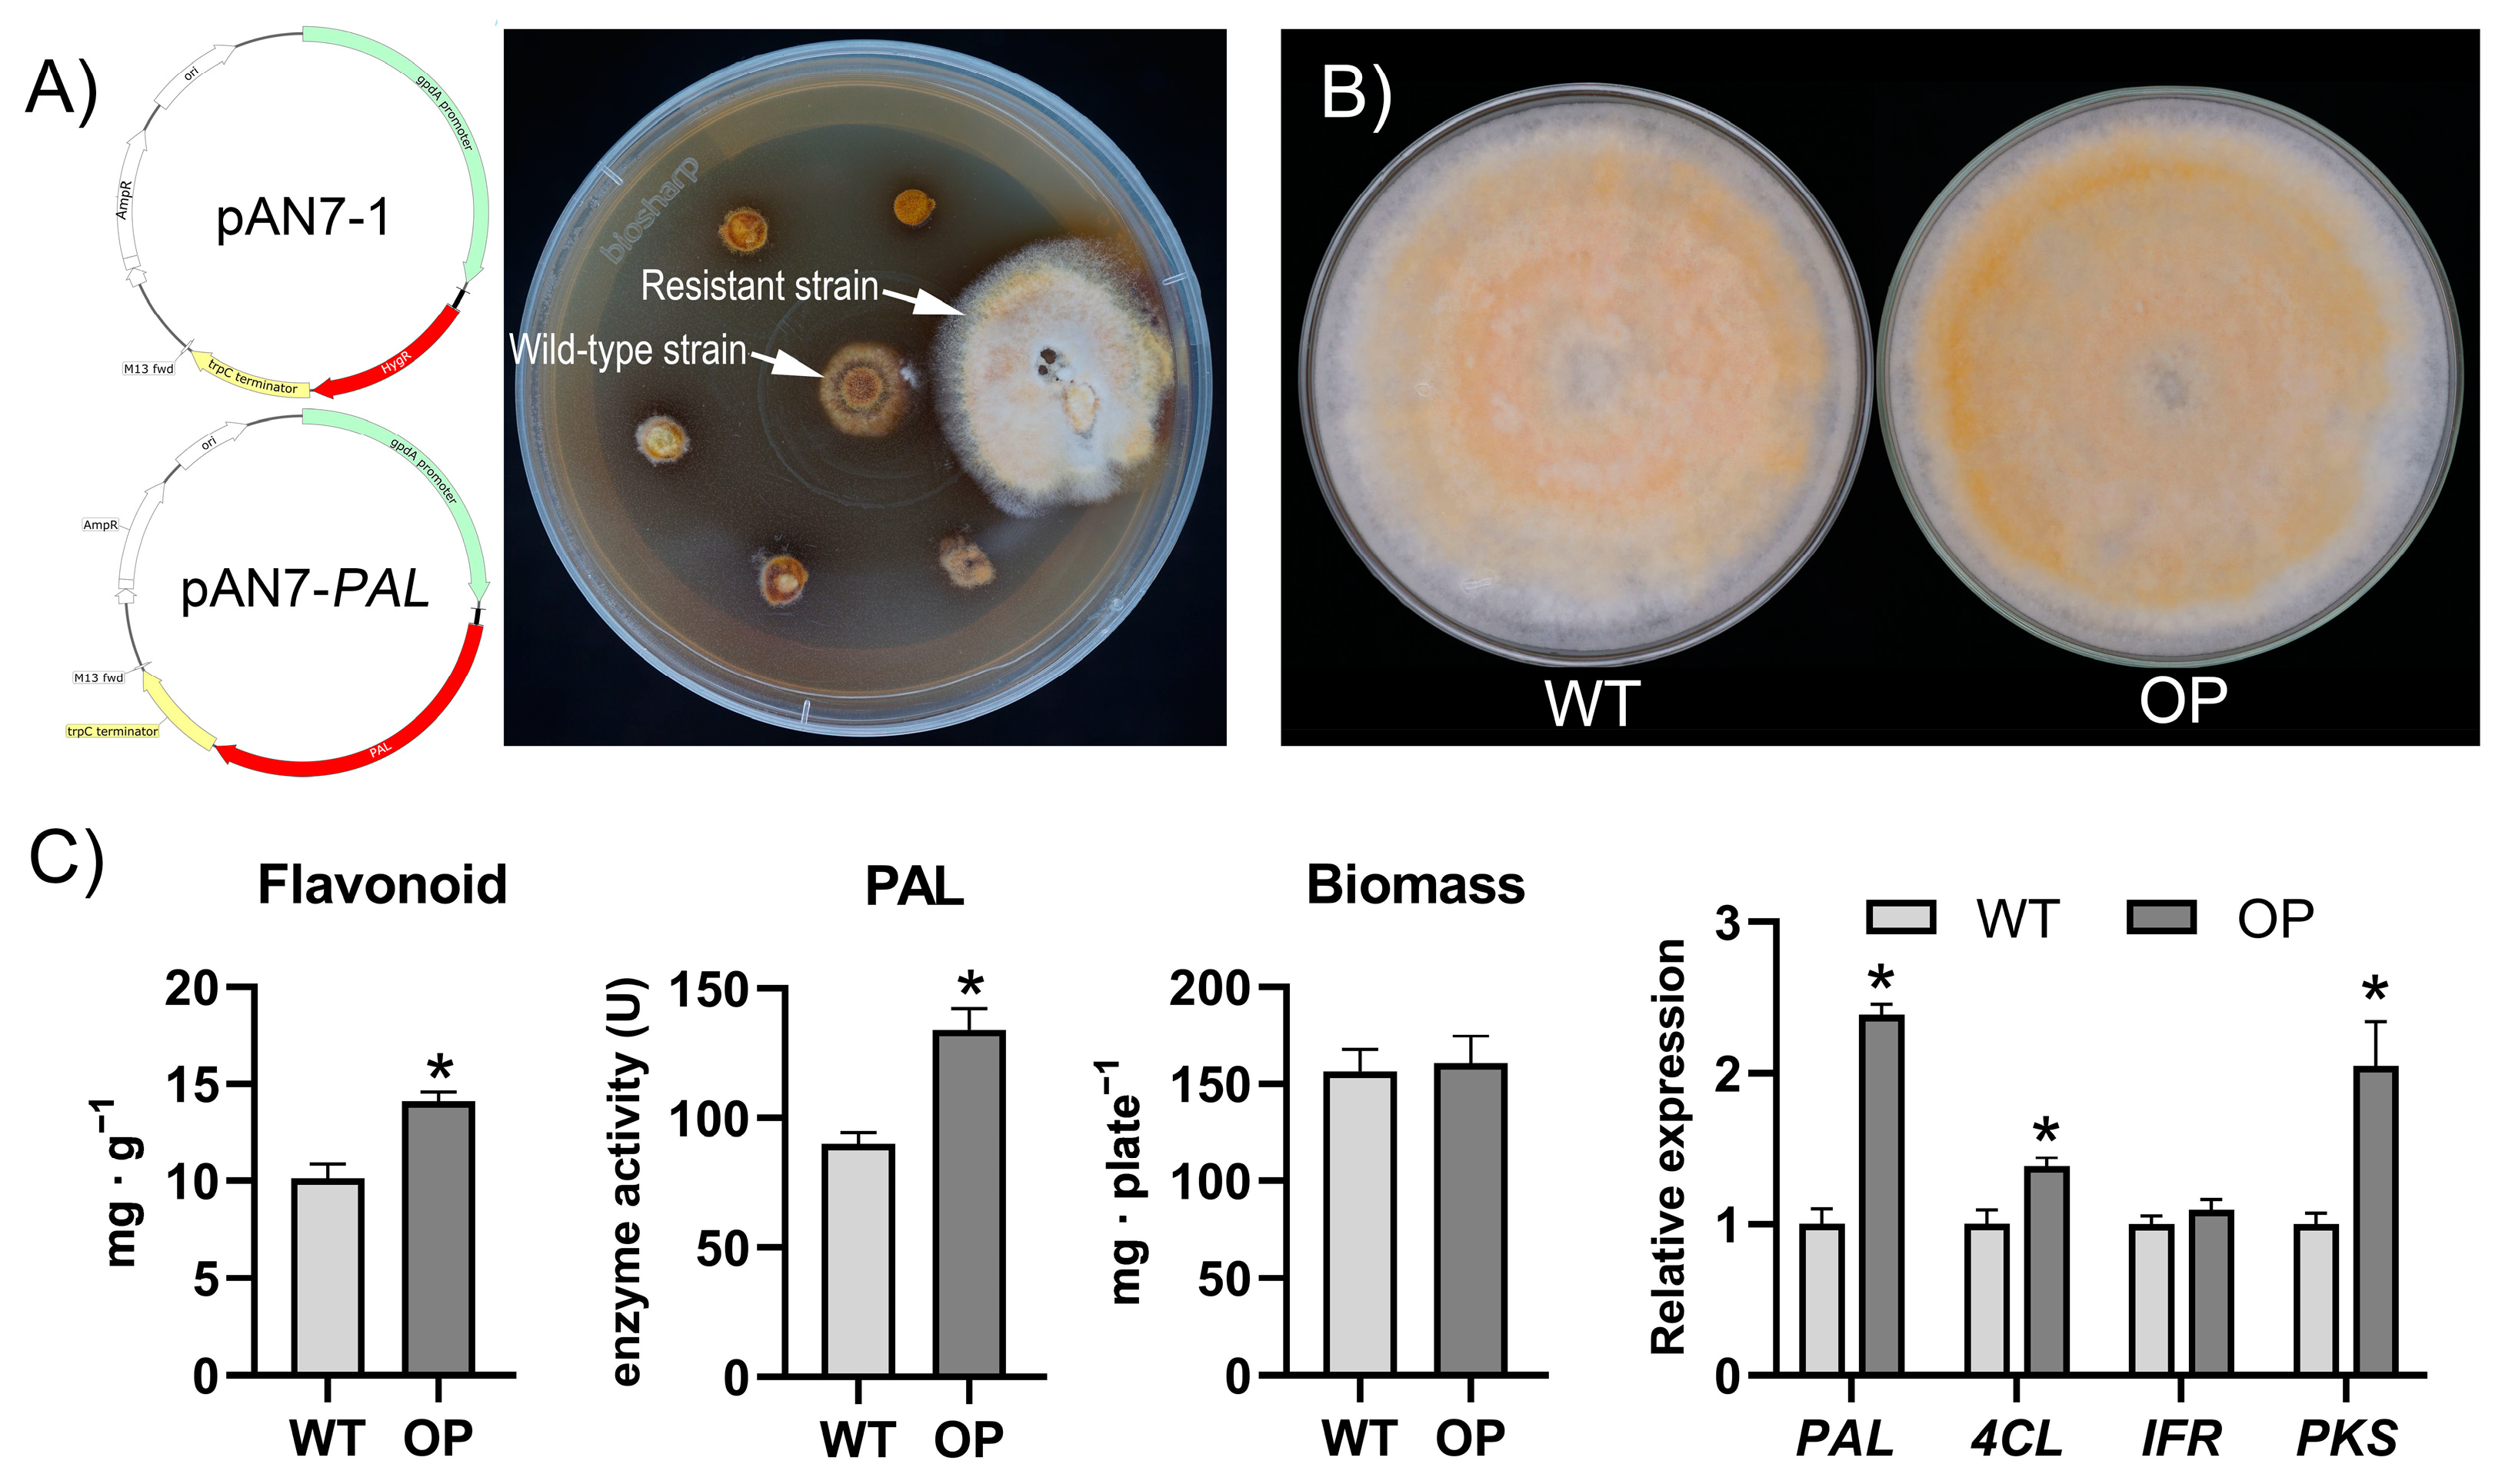

Mushrooms Do Produce Flavonoids: Metabolite Profiling and Transcriptome Analysis of Flavonoid Synthesis in the Medicinal Mushroom Sanghuangporus baumii
Abstract
:1. Introduction
2. Materials and Methods
2.1. Strain and Culture Conditions
2.2. Aeration Treatment
2.3. Determination of Bioactive Substance Contents and Enzyme Activity
2.4. Analysis of Flavonoids by UPLC–MS/MS
2.5. RNA Sequencing and Quantitative Real-Time Polymerase Chain Reaction (qRT-PCR) Analysis
2.6. PAL Gene Cloning and Bioinformatics Analysis
2.7. Purification and Functional Validation of PAL Protein
2.8. Plasmid Construction and Transformation of S. baumii Protoplasts
2.9. Statistical Analysis
3. Results
3.1. Determination of Flavonoids in S. baumii by UPLC–MS/MS
3.2. Aeration Promotes Flavonoid Accumulation in S. baumii
3.3. Metabolite Profiling and Transcriptome Analysis Reveals the Flavonoid Synthesis Pathway in S. baumii
3.4. Functional Analysis of SbPAL
3.5. Overexpression of the SbPAL Promotes Flavonoid Accumulation in S. baumii
4. Discussion
Supplementary Materials
Author Contributions
Funding
Institutional Review Board Statement
Informed Consent Statement
Data Availability Statement
Acknowledgments
Conflicts of Interest
References
- Maleki, S.J.; Crespo, J.F.; Cabanillas, B. Anti-inflammatory effects of flavonoids. Food Chem. 2019, 299, 125124. [Google Scholar] [CrossRef] [PubMed]
- Kopustinskiene, D.M.; Jakstas, V.; Savickas, A.; Bernatoniene, J. Flavonoids as Anticancer Agents. Nutrients 2020, 12, 457. [Google Scholar] [CrossRef] [PubMed] [Green Version]
- Gil-Ramírez, A.; Pavo-Caballero, C.; Baeza, E.; Baenas, N.; Garcia-Viguera, C.; Marín, F.R.; Soler-Rivas, C. Mushrooms do not contain flavonoids. J. Funct. Foods 2016, 25, 1–13. [Google Scholar] [CrossRef] [Green Version]
- Mohanta, T.K. Fungi contain genes associated with flavonoid biosynthesis pathway. J. Funct. Foods 2020, 68, 103910. [Google Scholar] [CrossRef]
- Nabavi, S.M.; Šamec, D.; Tomczyk, M.; Milella, L.; Russo, D.; Habtemariam, S.; Suntar, I.; Rastrelli, L.; Daglia, M.; Xiao, J.; et al. Flavonoid biosynthetic pathways in plants: Versatile targets for metabolic engineering. Biotechnol. Adv. 2018, 38, 107316. [Google Scholar] [CrossRef] [PubMed]
- Liu, M.-M.; Zeng, P.; Li, X.-T.; Shi, L.-G. Antitumor and immunomodulation activities of polysaccharide from Phellinus baumii. Int. J. Biol. Macromol. 2016, 91, 1199–1205. [Google Scholar] [CrossRef]
- Xue, Q.; Sun, J.; Zhao, M.; Zhang, K.; Lai, R. Immunostimulatory and anti-tumor activity of a water-soluble polysaccharide from Phellinus baumii mycelia. World J. Microbiol. Biotechnol. 2010, 27, 1017–1023. [Google Scholar] [CrossRef]
- Rai, A.; Saito, K.; Yamazaki, M. Integrated omics analysis of specialized metabolism in medicinal plants. Plant J. 2017, 90, 764–787. [Google Scholar] [CrossRef]
- Lau, W.; Sattely, E.S. Six enzymes from mayapple that complete the biosynthetic pathway to the etoposide aglycone. Science 2015, 349, 1224–1228. [Google Scholar] [CrossRef] [Green Version]
- Xu, L.; Li, S.; Shabala, S.; Jian, T.; Zhang, W. Plants Grown in Parafilm-Wrapped Petri Dishes Are Stressed and Possess Altered Gene Expression Profile. Front. Plant Sci. 2019, 10, 637. [Google Scholar] [CrossRef]
- Chai, X.; Maurer, R.; Hsieh, J.; Zhang, D.; Wang, S. Determination of acidic and basic species by headspace gas chromatography. J. Chromatogr. A 2005, 1093, 212–216. [Google Scholar] [CrossRef] [PubMed]
- Pękal, A.; Pyrzynska, K. Evaluation of Aluminium Complexation Reaction for Flavonoid Content Assay. Food Anal. Methods 2014, 7, 1776–1782. [Google Scholar] [CrossRef] [Green Version]
- Wang, S.; Liu, Z.; Wang, X.; Sun, T.; Zou, L. Cloning and characterization of a phosphomevalonate kinase gene from Sanghuangporus baumii. Biotechnol. Biotechnol. Equip. 2021, 35, 934–942. [Google Scholar] [CrossRef]
- Ren, H.; DU, N.; Niu, X.; Wang, Y.; Tian, H.; Cao, Y.; Zhang, B.; Fan, W. Inhibitory effects of L-3-phenyllacitc acid on the activity of mushnroom pholyphenol oxidase. Food Sci. Technol. 2021, 41, 343–351. [Google Scholar] [CrossRef]
- Sharma, P.; Kumar, A.; Bhardwaj, R. Plant steroidal hormone epibrassinolide regulate—Heavy metal stress tolerance in Oryza sativa L. by modulating antioxidant defense expression. Environ. Exp. Bot. 2016, 122, 1–9. [Google Scholar] [CrossRef]
- Zhao, H.; Li, G.; Guo, D.; Wang, Y.; Liu, Q.; Gao, Z.; Wang, H.; Liu, Z.; Guo, X.; Xu, B. Transcriptomic and metabolomic landscape of the molecular effects of glyphosate commercial formulation on Apis mellifera ligustica and Apis cerana cerana. Sci. Total Environ. 2020, 744, 140819. [Google Scholar] [CrossRef]
- Su, Y.; Zhang, J.; Xu, Z.; Li, J.; Wang, P.; Song, Z.; Tian, G.; Li, L.; Song, J.; Wang, J. Integrative analysis of metabolome and transcriptome reveals the mechanism of color formation in white root (Salvia miltiorrhiza). Ind. Crop. Prod. 2021, 170, 113784. [Google Scholar] [CrossRef]
- Li, G.; Li, R.; Liu, Q.; Wang, Q.; Chen, M.; Li, B. A highly efficient polyethylene glycol-mediated transformation method for mushrooms. FEMS Microbiol. Lett. 2006, 256, 203–208. [Google Scholar] [CrossRef]
- Rensing, S.A. Great moments in evolution: The conquest of land by plants. Curr. Opin. Plant Biol. 2018, 42, 49–54. [Google Scholar] [CrossRef]
- Sheng, H.; Sun, X.; Yan, Y.; Yuan, Q.; Wang, J.; Shen, X. Metabolic Engineering of Microorganisms for the Production of Flavonoids. Front. Bioeng. Biotechnol. 2020, 8, 589069. [Google Scholar] [CrossRef]
- Spagnuolo, C.; Russo, G.L.; Orhan, I.E.; Habtemariam, S.; Daglia, M.; Sureda, A.; Nabavi, S.F.; Devi, K.P.; Loizzo, M.R.; Tundis, R.; et al. Genistein and Cancer: Current Status, Challenges, and Future Directions. Adv. Nutr. 2015, 6, 408–419. [Google Scholar] [CrossRef] [PubMed] [Green Version]
- Bang, H.-J.; Ahn, M.-R. Antiangiogenic effect of pinobanksin on human umbilical vein endothelial cells. J. Funct. Foods 2021, 79, 104408. [Google Scholar] [CrossRef]
- Imran, M.; Salehi, B.; Sharifi-Rad, J.; Gondal, T.A.; Saeed, F.; Imran, A.; Shahbaz, M.; Fokou, P.V.T.; Arshad, M.U.; Khan, H.; et al. Kaempferol: A Key Emphasis to Its Anticancer Potential. Molecules 2019, 24, 2277. [Google Scholar] [CrossRef] [PubMed] [Green Version]
- Keller, N.P. Fungal secondary metabolism: Regulation, function and drug discovery. Nat. Rev. Microbiol. 2019, 17, 167–180. [Google Scholar] [CrossRef] [PubMed]
- Yuan, H.-S.; Lu, X.; Dai, Y.-C.; Hyde, K.D.; Kan, Y.-H.; Kušan, I.; He, S.-H.; Liu, N.-G.; Sarma, V.V.; Zhao, C.-L.; et al. Fungal diversity notes 1277–1386: Taxonomic and phylogenetic contributions to fungal taxa. Fungal Divers. 2020, 104, 1–266. [Google Scholar] [CrossRef]
- Dong, N.; Lin, H. Contribution of phenylpropanoid metabolism to plant development and plant–environment interactions. J. Integr. Plant Biol. 2020, 63, 180–209. [Google Scholar] [CrossRef]
- Jiao, C.; Sørensen, I.; Sun, X.; Sun, H.; Behar, H.; Alseekh, S.; Philippe, G.; Lopez, K.P.; Sun, L.; Reed, R.; et al. The Penium margaritaceum Genome: Hallmarks of the Origins of Land Plants. Cell 2020, 181, 1097–1111.e1012. [Google Scholar] [CrossRef]
- James, A.M.; Ma, D.; Mellway, R.; Gesell, A.; Yoshida, K.; Walker, V.; Tran, L.; Stewart, D.; Reichelt, M.; Suvanto, J.; et al. Poplar MYB115 and MYB134 Transcription Factors Regulate Proanthocyanidin Synthesis and Structure. Plant Physiol. 2017, 174, 154–171. [Google Scholar] [CrossRef]
- Kawatra, A.; Dhankhar, R.; Mohanty, A.; Gulati, P. Biomedical applications of microbial phenylalanine ammonia lyase: Current status and future prospects. Biochimie 2020, 177, 142–152. [Google Scholar] [CrossRef]
- Liu, R.; Xu, S.; Li, J.; Hu, Y.; Lin, Z. Expression profile of a PAL gene from Astragalus membranaceus var. Mongholicus and its crucial role in flux into flavonoid biosynthesis. Plant Cell Rep. 2006, 25, 705–710. [Google Scholar] [CrossRef]
- Olsen, K.M.; Lea, U.S.; Slimestad, R.; Verheul, M.; Lillo, C. Differential expression of four Arabidopsis PAL genes; PAL1 and PAL2 have functional specialization in abiotic environmental-triggered flavonoid synthesis. J. Plant Physiol. 2008, 165, 1491–1499. [Google Scholar] [CrossRef] [PubMed]

Publisher’s Note: MDPI stays neutral with regard to jurisdictional claims in published maps and institutional affiliations. |
© 2022 by the authors. Licensee MDPI, Basel, Switzerland. This article is an open access article distributed under the terms and conditions of the Creative Commons Attribution (CC BY) license (https://creativecommons.org/licenses/by/4.0/).
Share and Cite
Wang, S.; Liu, Z.; Wang, X.; Liu, R.; Zou, L. Mushrooms Do Produce Flavonoids: Metabolite Profiling and Transcriptome Analysis of Flavonoid Synthesis in the Medicinal Mushroom Sanghuangporus baumii. J. Fungi 2022, 8, 582. https://doi.org/10.3390/jof8060582
Wang S, Liu Z, Wang X, Liu R, Zou L. Mushrooms Do Produce Flavonoids: Metabolite Profiling and Transcriptome Analysis of Flavonoid Synthesis in the Medicinal Mushroom Sanghuangporus baumii. Journal of Fungi. 2022; 8(6):582. https://doi.org/10.3390/jof8060582
Chicago/Turabian StyleWang, Shixin, Zengcai Liu, Xutong Wang, Ruipeng Liu, and Li Zou. 2022. "Mushrooms Do Produce Flavonoids: Metabolite Profiling and Transcriptome Analysis of Flavonoid Synthesis in the Medicinal Mushroom Sanghuangporus baumii" Journal of Fungi 8, no. 6: 582. https://doi.org/10.3390/jof8060582
APA StyleWang, S., Liu, Z., Wang, X., Liu, R., & Zou, L. (2022). Mushrooms Do Produce Flavonoids: Metabolite Profiling and Transcriptome Analysis of Flavonoid Synthesis in the Medicinal Mushroom Sanghuangporus baumii. Journal of Fungi, 8(6), 582. https://doi.org/10.3390/jof8060582

